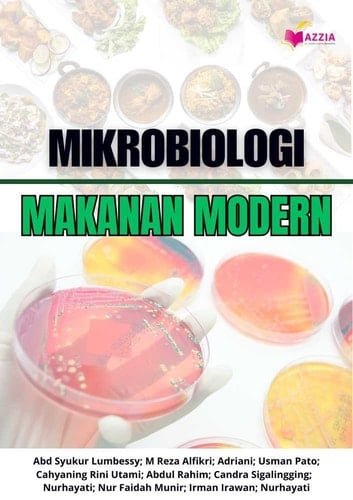
MIKROBIOLOGI MAKANAN MODERN

Buku ini membahas secara komprehensif tentang mikroorganisme yang berperan dalam makanan, baik yang menguntungkan maupun yang merugikan. Mikroorganisme memiliki peran penting dalam industri pangan, mulai dari proses fermentasi yang menghasilkan produk bernilai tambah hingga potensi kontaminasi yang dapat menimbulkan risiko kesehatan. Pembahasan dimulai dari dasar-dasar mikrobiologi makanan, termasuk sejarah perkembangannya, hingga aplikasi mutakhir dalam teknologi pangan dan keamanan pangan modern. Dengan pemahaman yang mendalam, buku ini memberikan wawasan tentang bagaimana mikroorganisme dapat dimanfaatkan dan dikendalikan dalam berbagai aspek produksi pangan. Selain itu, buku ini juga menyoroti aspek keamanan pangan dengan membahas patogen bawaan makanan serta metode pencegahan dan pengendaliannya, termasuk sistem Hazard Analysis and Critical Control Points (HACCP). Keamanan pangan menjadi aspek krusial dalam industri pangan modern, di mana regulasi dan standar mutu terus dikembangkan untuk memastikan produk pangan yang aman bagi konsumen. Berbagai teknik pengawetan pangan, seperti pasteurisasi, pendinginan, dan penggunaan bahan pengawet alami, juga dikaji dalam buku ini untuk menunjukkan bagaimana strategi mikrobiologi dapat diterapkan dalam memperpanjang umur simpan makanan.
Page Count:
287
Publication Date:
2025-04-29
ISBN-10:
6238986921
ISBN-13:
9786238986927
No comments yet. Be the first to share your thoughts!